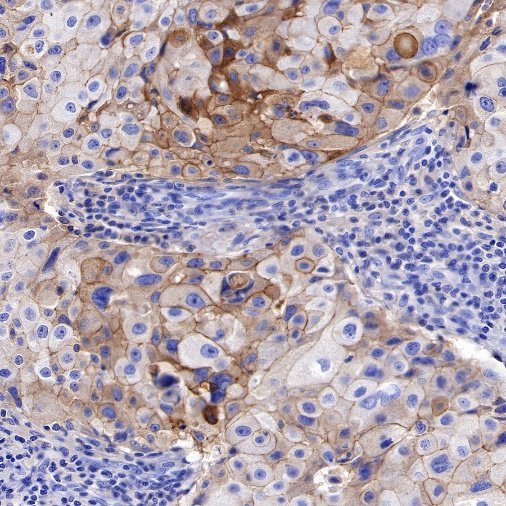
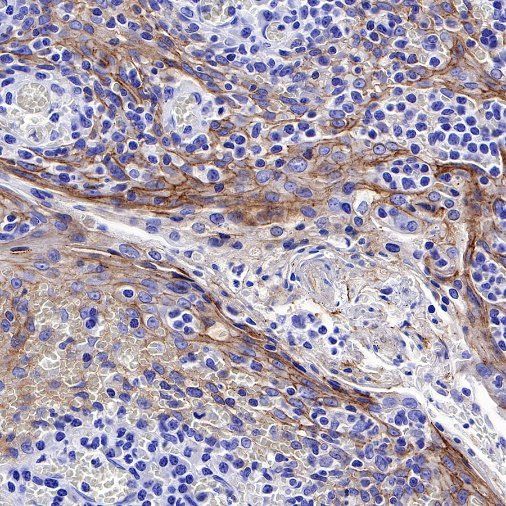
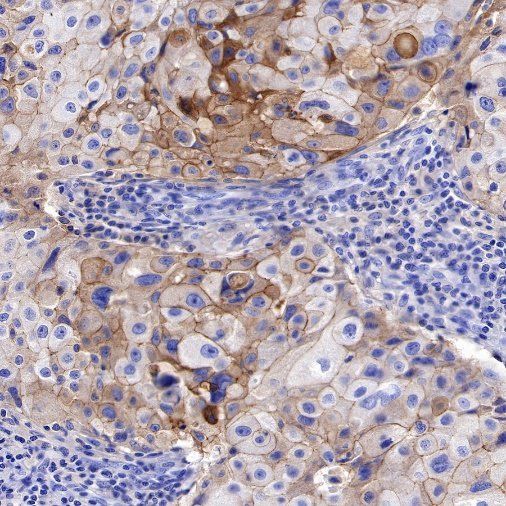

Product Specification
| Host |
Rabbit |
| Antigen |
NECTIN-4 |
| Synonyms |
LNIR, PRR4, PVRL4 |
| Immunogen |
Recombinant Protein |
| Location |
Cell membrane |
| Accession |
Q96NY8 |
| Clone Number |
SDT-277-314-1 |
| Antibody Type |
Recombinant mAb |
| Isotype |
IgG |
| Application |
WB, IHC-P |
| Reactivity |
Hu |
| Purification |
Protein A |
| Concentration |
0.5 mg/ml |
| Conjugation |
Unconjugated |
| Physical Appearance |
Liquid |
| Storage Buffer |
PBS, 40% Glycerol, 0.05%BSA, 0.03% Proclin 300 |
| Stability & Storage |
12 months from date of receipt / reconstitution, -20 °C as supplied
|
Dilution
| application |
dilution |
species |
| WB |
1:1000 |
null |
| IHC-P |
1:500 |
null |
Background
Nectin-4 (Nectin cell adhesion molecule 4) is a type I transmembrane cell adhesion molecule belonging to the Nectin family. A homolog formerly known as the poliovirus receptor (PVR/CD155) is also known as the poliovirus receptor associated (PRR) protein. During physiological development, Nectin-4 is specifically expressed during embryonic and fetal development and is very low expressed in adult tissues. It forms physical connections between neighboring cells and is essential for enabling intercellular communication, migration, and other important cellular processes.
Nectin-4 is overexpressed in a variety of tumor cells, and Nectin-4 is used as a marker for cancer recurrence and metastasis, which is associated with poor prognosis of a variety of cancers, including uroepithelial carcinoma, breast cancer, ovarian cancer, pancreatic cancer, non-small cell lung cancer, gastric cancer, hepatocellular carcinoma and bladder cancer. Nectin-4 can promote tumor cell proliferation and differentiation, angiogenesis, lymphangiogenesis and lymphatic metastasis through activation of PI3K/AKT pathway, playing an important role in the occurrence and metastasis of cancer. Nectin-4 is also an independent biomarker associated with poor overall survival in some cancer types. Due to its high specific expression in tumors, drug studies targeting this target have emerged.